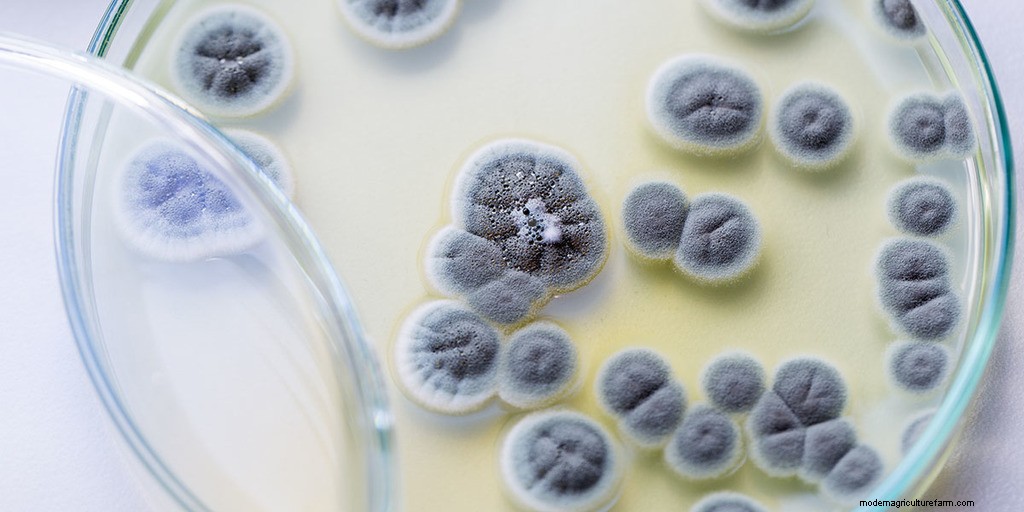

Are mushrooms vegetables? No, they are a type of fungi. Technically mushrooms aren’t plants, so they aren’t classified as either fruits or vegetables. They belong to their own separate kingdom. But for practical purposes, we often treat mushrooms as vegetables in the kitchen in terms of how we prepare them.
In this article, I’ll explain what a vegetable is, as well as what a fungus is. I’ll explain why from a biology perspective, mushrooms aren’t plants. But in the kitchen we typically still treat them as if they were vegetables.

All vegetables and fruits come from plants.
Vegetables can be a special part of the plant that it uses to reproduce. This is the case with tomatoes, peppers, artichokes, cucumbers, eggplants, beans, peas, and a number of other vegetables and fruits.
For other vegetables, we eat all or most of the plant itself, like with onions, spinach, lettuce, cauliflower, or celery.
The main thing that all plants have in common is that they gather energy from the sun and use chlorophyll contained in their cells to convert it into energy.
Chlorophyll is what gives the vast majority of plants their signature green color.

Mushrooms don’t contain chlorophyll. They don’t turn sunlight into energy. Instead, they get the nutrients they need from dead and decaying matter, or from the root systems of living plants.
So they are categorized as a separate kingdom of life called fungi. Other members of the fungi kingdom include yeasts and molds.
Mushrooms can be divided into three broad categories:
The mushrooms that we eat are only a small part of the overall fungus. Underground or inside trees, mushrooms start off as a white fluffy root system called mycelium.
This makes up the majority of the fungus and most of its life is spent in this stage. Mycelium can stay hidden for years until humidity, temperature, and other factors are just right before they will create mushrooms.
Mushrooms are the fruit of the fungus. They grow up and open to release spores, which are basically like the seeds of a fungus.
These spores drop or are carried by the wind and begin to grow another mycelium colony somewhere else.

If mushrooms aren’t biologically a vegetable, then it stands to reason that they aren’t a fruit either, right?
While mushrooms aren’t technically a fruit, they are actually closer to a fruit than a vegetable.
The mushrooms that we know and love are actually a tiny part of the much larger living, growing part of the mushroom called mycelium that grows under the ground or in logs.
The mushrooms you see are the reproductive part of the fungi. Their purpose is to grow and spread the reproductive bits of the mushroom. These are called spores, which are essentially the seeds of a mushroom.
So in that way, mushrooms are kind of like a fruit. The only difference is that they don’t come from plants, and they don’t require pollination or flowers which are usually needed to produce fruit in the plant kingdom.

Do mushrooms count as vegetables when we’re cooking? When we look at mushrooms in the kitchen, they are considered to be vegetables for practical purposes. We cook mushrooms in many of the same ways that we cook vegetables.
We can set the science aside when it comes to preparing food. Technically tomatoes and peppers are also fruits, but for the purposes of cooking we usually consider them to be vegetables.
When we’re trying to prepare a meal, it matters a lot more what something tastes like, as opposed to the technical details of its biology or how it reproduces.
Although mushrooms are cooked like vegetables, they also make a great meat substitute due to their meaty texture and savory flavor.
A large portobello cap makes a great substitute for a beef burger patty and when sliced into pinky sized strips they’re a perfect finger food for babies, or you can chop mushrooms up to use them in place of meat in tacos, chili, or all kinds of other dishes.
Here you can learn 30 Of The Best Mushroom Recipe Ideas and different ways of cooking them.
It’s worth noting that the biological kingdoms of life are human-made. They aren’t an absolute fact of nature. Instead, they’re just a way that scientists categorize different lifeforms on our planet for the sake of convenience.
We agree on specific characteristics that separate different lifeforms, to determine which kingdom they belong to.
In fact, mushrooms were considered to be a primitive part of the plant kingdom up until 1969. Previously there were only four kingdoms of life: Monera, Protista, Plantae, and Animalia. In 1969, Robert Harding Whittaker proposed a fifth kingdom of Fungi.
This taxonomical system is constantly changing and being updated. As of 2015, scientists now classify life into seven kingdoms: Bacteria, Archaea, Protozoa, Chromista, Plantae, Fungi, and Animalia.
Since there are such a large number of fungi species that exist, it warranted giving them their own kingdom to help classify them and keep them separate from plants.
But really nature doesn’t make this distinction, and often the line can be blurred between what is a plant, animal, or fungus.
For example, think of carnivorous plants like venus fly traps which can actually trap and digest insects and even small animals like frogs.
The main differences between plants, animals, and fungi are:

For nutritional purposes, the US Department of Agriculture classifies mushrooms as vegetables. This is because they contain many of the same nutritional benefits that vegetables offer.
But they also offer many nutrients that are less-commonly found in vegetables.
For example, mushrooms are also a good source of vitamin D, B vitamins, niacin, selenium, copper, and pantothenic acid. So they help to bridge the gap between nutrients available in plants, grains, and meat.
There are a wide variety of different kinds of edible mushrooms. They all have their own unique textures, shapes, flavors, as well as nutritional profiles.
Mushrooms can also be considered an adaptogenic food. That means they help your body deal with various kinds of stress and help to promote normal physical function.
Many mushroom species like chaga and lion’s mane can be used to boost your immune system.
Mushrooms are also full of antioxidants and may even have anti-aging properties.
The compounds that mushrooms contain are great at neutralizing free radicals, which are molecules that can wreak havoc on your body and lead to cancer and other nasty diseases.
Even dogs can eat mushrooms for healthy nutrition. Learn which mushrooms are safe for dogs to eat.
In fact, button mushrooms are even better than vegetables like green beans, tomatoes, carrots, and peppers when it comes to antioxidant content.
The best part is that the antioxidants contained in mushrooms aren’t destroyed or inactivated when cooked.

If you’re interested in taking advantage of the many possible health benefits that mushrooms offer, there are lots of ways of adding them to your diet.
You can buy mushroom teas, supplements, or take them in other medicinal forms. But it’s a much more enjoyable experience to simply cook with them instead!
Why not prepare some nutritious meals for you and your family while also taking advantage of the numerous health benefits that mushrooms can offer?
Most types of mushrooms can be thinly sliced and sauteed in some oil or butter and they have a low carb count making them keto-friendly. You can also add them to stir-frys like any other vegetable. Or you can substitute them for some ground meat in many recipes.
Some mushrooms like enoki are great even when eaten raw, and can be added to salads. (Not all mushrooms can be eaten raw though, so be sure to check.)
If you don’t want to buy fresh mushrooms and risk them going bad before you get a chance to use them, you can also get dried mushrooms.
You can easily reconstitute dried mushrooms in some warm water, and then add them to casseroles, soups, or any number of other recipes.
The water you soak them in can be used to add some extra flavor to rice, soups, or stews or used to make a gravy.
For some more information on how to store, clean, prepare, and cook mushrooms check these articles:

If the mushrooms at your local grocery store seems a bit too pricey for you, or their selection is lacking, you have a few other options.
You could go foraging for wild mushrooms, or you could try to grow your own mushrooms.
Wild mushrooms can be a great delicacy, but I’d highly discourage against trying to gather your own unless you know what you’re doing.
There are many types of poisonous mushrooms out there that look very similar to many popular edible varieties. Sometimes only an expert can tell the difference, so I wouldn’t take the risk.
There is an old saying that there are only two types of mushroom hunters. There are bold ones and old ones, but there are no old bold mushroom hunters.
In other words, taking risks usually doesn’t pay off when it comes to foraging for wild mushrooms.
The good news is that growing mushrooms of your own is an excellent alternative. There are kits that you can buy that make the process super easy.
In some cases, all you need to do is mist the container with water a couple of times per day, and you should have some of your own fresh and delicious mushrooms in just a couple of weeks.
You can check out my article How To Grow Mushrooms: The Ultimate Guide to learn more.
For beginners, I always recommend starting with oyster mushrooms. But for those with some more experience and a bit of patience, shiitake mushrooms are fairly easy to grow for beginners as well.

There are over 2,000 varieties of edible mushrooms. But there are only a handful which are commercially grown and sold, at least in our part of the world.
The most common type of mushroom by far is agaricus bisporus. This species includes white button mushrooms, cremini mushrooms, and portobello mushrooms.
Most people are familiar with this type of mushroom on their pizza or in pasta sauce. These mushrooms are sold in nearly every supermarket and grocery store produce section.
According to the US Department of Agriculture, the average American eats a little less than 3 pounds of fresh white mushrooms per year.
Oyster mushrooms and shiitake mushrooms are probably the next-most common variety of edible mushrooms.
You might not find these in every grocery store, they’ll be more commonly found in Asian markets. Sometimes you’ll also find tiny enoki mushrooms for sale as well.
Some of the most delicious edible mushrooms include morels, chanterelles, and truffles. But unfortunately, these mushrooms are very difficult to commercially cultivate, so you’ll almost never see them in stores.
If you’re lucky, you might be able to find them at your local farmer’s market when they’re in season. Otherwise, you’ll likely need to have a friend who is an expert mushroom forager if you hope to taste them.
If you’re interested in learning more details about these varieties of mushrooms and many others, you can check out my article 20 Popular Types Of Mushrooms (And Their Uses.)

If you’re environmentally-conscious, then you probably pay close attention to where your food comes from. Eating locally and supporting sustainable agriculture is becoming more and more popular.
Mushrooms are in fact a very sustainable food choice.
Mushroom farms are able to recycle byproducts like crushed up corn cobs, cocoa shells, peanut and soybean hulls from other agricultural sectors, and even waste such as coffee grounds from coffee shops.
These materials form a nutrient-rich substrate that mushrooms can be grown on, which would otherwise be wasted.
Once the mushrooms are done growing, the spent substrate can be composted to create a great soil amendment that also has the benefits of added fungi.
Since commercial mushrooms are almost exclusively grown indoors, they take up much less land space than conventional crops.
Growers are able to better control environmental factors in this setting, which saves on water use and other energy needs.
Modern mushroom farms are very energy efficient and have a very small carbon footprint when compared to conventional agriculture.
Some mushroom farms even use the heat generated from composting to warm their facilities!
Since mushrooms have a short shelf life, they don’t travel well. So most mushrooms that you find in stores are grown locally, instead of being transported from other continents like some fruits and vegetables.
There is some argument about whether mushrooms are considered vegan-friendly food or not, read my article Are Mushrooms Vegan?
From a biological perspective, mushrooms are not vegetables. In fact, they aren’t plants at all. They have been classified as their own kingdom of life called fungi for the past 50 years or so.
The fungi kingdom also includes other lifeforms like yeasts and molds. Before then, mushrooms were regarded as a primitive form of plant however.
Taxonomy is a human-created invention that is mostly used for practical purposes, as it allows scientists to easily classify various lifeforms.
In a practical sense when it comes to cooking, mushrooms are most often treated like a vegetable.
They can be used in many recipes like stir fries, stews, or sauces where you would normally incorporate vegetables. Mushrooms also make a great side dish on their own when simply sauteed in some butter or oil. Find more delicious recipes in my 25 Of The Best Vegan Mushroom Recipes article.
So while mushrooms aren’t technically a vegetable, you can think of them and treat them like one in the kitchen.